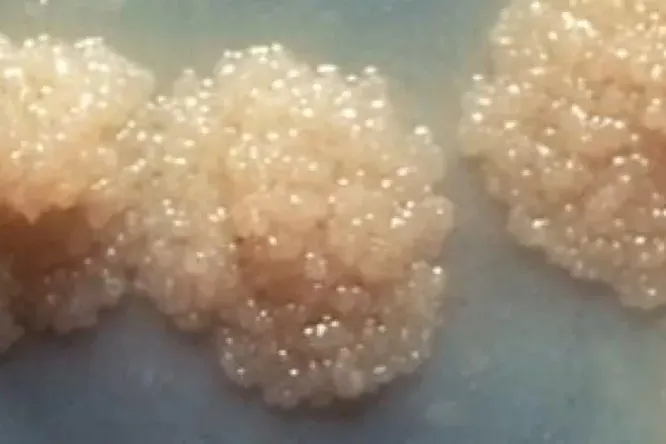
Туберкулез отобрал у COVID'а звание самой смертоносной инфекции

Туберкулез отобрал у COVID'а звание самой смертоносной инфекции

Мел Спигельман, президент некоммерческого Альянса по борьбе с туберкулезом, приветствовал быстрый и впечатляющий прогресс в борьбе с пандемией COVID-19 благодаря широкому спектру безопасных и эффективных вакцин, тестов и методов лечения, разработанных в течение двух лет. «Но сопоставление с туберкулезом довольно резкое», — заявил он в недавнем интервью.
Туберкулез, когда-то называвшийся чахоткой, был самой крупной инфекционной причиной смерти в мире до появления COVID-19: ежегодно от этой болезни умирало 1,5 миллиона человек. В условиях неуклонного снижения глобальной смертности от COVID-19 «туберкулез вновь обрел сомнительное признание», — отметил Шпигельман.
The TB Alliance, некоммерческая организация, работающая над разработкой и поставкой быстродействующих и доступных по цене лекарств против этой болезни, особенно в более бедных странах, отмечает, что, исходя из ежегодного уровня смертности, туберкулез убивает 4109 человек в день.
Это сопоставимо с 1449 людьми в день, умирающими из-за COVID-19, рассчитанными на основе 40 578 смертей, зарегистрированных за последние 28 дней на приборной панели Университета Джона Хопкинса.
